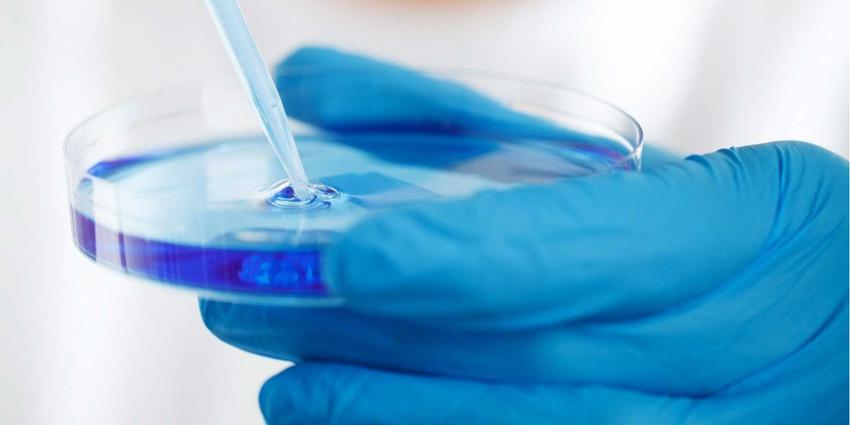
laboratorium-petris-pipet

Tielen wil limiet op buitenlands donorzaad
Het ontstaan van grote verwantschapsnetwerken als gevolg van donorconceptie met buitenlands donorsperma moet worden tegengegaan. Daarom onderzoekt staatssecretaris Tielen (Jeugd, Preventie en Sport) de mogelijkheden om het gebruik van donorsperma uit verschillende landen te reguleren via de Wet zeggenschap lichaamsmateriaal en via Europese regelgeving. Verder pleit de staatssecretaris voor het maken van striktere afspraken tussen alle betrokken partijen rond grensoverschrijdende donorconceptie.
Staatssecretaris Tielen: “De afgelopen jaren vindt donorconceptie steeds meer plaats in een internationale context, mede vanwege het tekort aan spermadonoren in Nederland. We zien dat dit tot problemen kan leiden, zoals het ontstaan van grote verwantschapsnetwerken. Dat is zorgwekkend. Het afstammen van ‘massadonoren’ en hebben van soms wel tientallen tot honderden halfzussen en -broers wordt door een deel van deze kinderen ervaren als een pijnlijke last. Ook klinkt vanuit medisch-ethisch, juridisch en politiek perspectief een steeds luidere roep om dergelijke praktijken rond donorconceptie beter te reguleren. Daarom stel ik deze maatregelen voor.”
Gevolgen gebruik buitenlands donorsperma
Voor het gebruik van donorsperma in Nederlandse klinieken geldt een limiet van twaalf vrouwen per donor. Andere landen hanteren vaak een limiet voor het aantal nakomelingen van één donor binnen dat land. Maar als sperma in meerdere landen wordt gebruikt, kan het totaal aantal nakomelingen van die donor flink oplopen. De internationaal opererende spermabanken leveren sperma van een donor vaak aan meerdere klinieken in Europa of zelfs wereldwijd. Massadonatie en het gebruik van buitenlands donorsperma kan verschillende negatieve gevolgen hebben voor donorkinderen, zoals geen contact kunnen leggen met donoren en de psychische druk van grote verwantschapsnetwerken.
Wetgeving
Om het belang van het toekomstige (donor)kind te beschermen, onderzoekt de staatssecretaris verschillende routes waarmee het gebruik van buitenlands sperma kan worden gereguleerd. De beste kans op regulering van grensoverschrijdend gebruik van donorsperma is het Wetsvoorstel zeggenschap lichaamsmateriaal (Wzl), dat momenteel voor behandeling in de Tweede Kamer ligt. Het voorstel is om zowel de invoer als de export van donorsperma te verbieden, behalve als in bindende afspraken is vastgelegd dat het donorsperma wereldwijd bij niet meer dan een bepaald aantal gezinnen ingezet wordt.
Ook op Europees niveau blijft de staatssecretaris pleiten voor een maximum aantal gezinnen per donor. Mede aangewakkerd door recente misstanden, lijkt Europese regulering van de omvang van grensoverschrijdende donorconceptie steeds meer steun te krijgen.
Gezamenlijke verantwoordelijkheid
De ontwikkeling van wet- en regelgeving kan lang duren en lost niet alle problemen op. Daarom is op korte termijn meer te verwachten van zelfregulering, afspraken tussen partijen en gezamenlijke initiatieven. De verantwoordelijkheid voor verantwoorde donorconceptie ligt naast de overheid ook bij wensouders, klinieken, spermabanken en behandelend artsen. Daarom gaat het ministerie binnenkort om tafel met alle betrokken partijen om de praktijken rond grensoverschrijdende donorconceptie te verbeteren.
